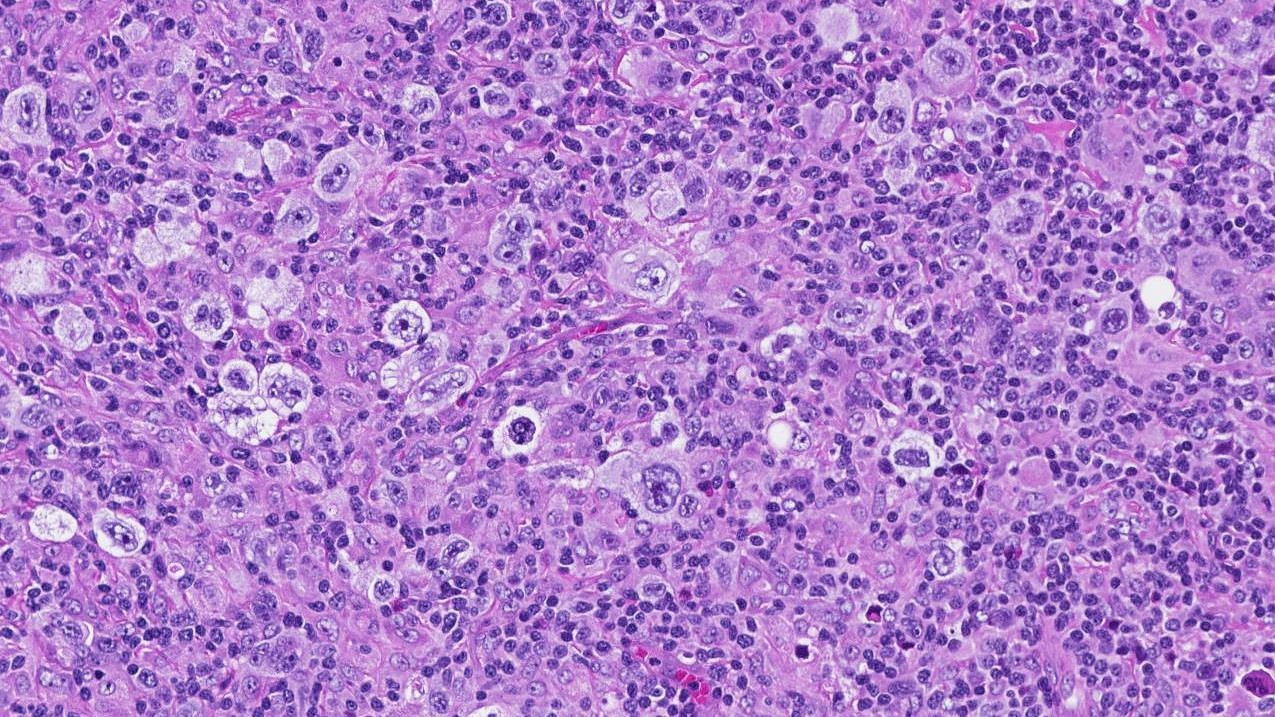
ランニング中の怪我について

ランニングは、フィットネスを向上および維持し、体型を維持するための最も人気のある方法の 1 つになっています。実際には、それ以上の
ランニングはアクティブに過ごすのに最適な方法ですが、多くのランナーはいつかは怪我に対処しなければなりません。
ランニング中の怪我の最も一般的な種類、典型的な症状、およびその治療方法について詳しく知るには、読み続けてください。
ランニング中の怪我について
あなたも多くのランナーと同じであれば、年間数百マイル、場合によっては数千マイルを記録しているかもしれません。こうした足の打撃による繰り返しの衝撃は、筋肉、関節、結合組織にダメージを与える可能性があります。
によると
- 膝: 7.2 ~ 50%
- 下腿: 9.0 ~ 32.2 パーセント
- 大腿部: 3.4 ~ 38.1 パーセント
- 足: 5.7 ~ 39.3 パーセント
- 足首: 3.9 ~ 16.6%
- 股関節、骨盤、または鼠径部: 3.3 ~ 11.5 パーセント
- 腰部: 5.3 ~ 19.1%
ランナーに影響を与える最も一般的な怪我のいくつかを詳しく見てみましょう。

1. ランナー膝(膝蓋大腿症候群)
ランナー膝、または膝蓋大腿症候群は、膝の前または膝蓋骨の周りの痛みを指す一般用語です。これは、走ったりジャンプしたりするスポーツでよく見られる使いすぎによる損傷です。
股関節や膝周囲の筋肉が弱ると、ランナー膝を発症するリスクが高くなります。
ランナー膝は次のような痛みを引き起こす可能性があります。
- 鈍くて、片方または両方の膝に感じることがある
- 軽いものから非常に痛いものまであります
- 長時間座ったり運動したりすると悪化する
- ジャンプしたり、階段を上ったり、しゃがんだりすると悪化する
この種の損傷により、長時間静止した後に、亀裂やパチパチという音が発生する場合もあります。
医師は多くの場合、健康診断でランナー膝を診断できますが、他の疾患を除外するために X 線検査を推奨する場合もあります。理学療法士は、ランナー膝の損傷を治療するための具体的な治療計画を提供できます。

2.アキレス腱炎
アキレス腱炎とは、ふくらはぎの筋肉とかかとを繋ぐ腱の炎症を指します。走行距離を増やしたり、ランニングの強度を上げたりした後に起こることがあります。
アキレス腱炎を治療せずに放置すると、アキレス腱が断裂するリスクが高まります。この腱が断裂した場合、通常は修復するために手術が必要になります。
アキレス腱炎の一般的な症状は次のとおりです。
- 下腿のかかとの上の鈍い痛み
- アキレス腱に沿って腫れる
- 足をすねに向かって曲げるときの可動域の制限
- 腱に温かい感触

3.ITバンド症候群
一般に IT バンドと呼ばれる腸脛靱帯は、股関節の外側から膝まで伸びる長い結合組織です。この組織の帯は、歩いたり走ったりするときに膝を安定させるのに役立ちます。
IT バンド症候群は、 IT バンドが脚の骨に繰り返し擦れることによって引き起こされます。 IT バンドがきついため、ランナーによく見られます。臀部の筋肉、腹筋、または腰の筋力が弱いことも、この症状の一因となる可能性があります。
IT バンド症候群は、脚の外側、通常は膝のすぐ上に鋭い痛みを引き起こします。あなたの IT バンドも触ると優しいかもしれません。膝を曲げると痛みが悪化することがよくあります。

4. シンスプリント
シンスプリント(脛骨ストレス症候群)とは、下肢の前部または内側、すねの骨に沿って生じる痛みを指します。シンスプリントは、特に硬い路面を走るときにランニング量を急激に増やしすぎると発生することがあります。
ほとんどの場合、シンスプリントは深刻なものではなく、休むと治ります。しかし、治療せずに放置すると疲労骨折に発展する可能性があります。
シンスプリントの症状には次のようなものがあります。
- すねの骨の前部または内側に沿った鈍い痛み
- 運動すると痛みが悪化する
- 触れると優しさ
- 軽い腫れ
シンスプリントは、休息をとるか、走る頻度や距離を減らすことでよくなることがよくあります。

5. ハムストリングの怪我
ハムストリングスは、ランニングサイクルのスイング段階で下肢を減速させるのに役立ちます。ハムストリングスが硬かったり、弱かったり、疲れていたりすると、怪我をしやすくなる可能性があります。
スプリンターとは異なり、長距離ランナーが突然ハムストリングの断裂を経験することはかなりまれです。ほとんどの場合、長距離ランナーはハムストリングの緊張を経験しますが、これはゆっくりと起こり、ハムストリングの筋肉の線維や結合組織に小さな断裂が繰り返されることによって引き起こされます。
ハムストリングを損傷すると、次のような症状が起こる可能性があります。
- 上腿の後ろの鈍い痛み
- 触れると柔らかいハムストリングの筋肉
- ハムストリングの弱さと硬さ

6. 足底筋膜炎
足底筋膜炎は、最も一般的な足の怪我の 1 つです。これには、足の裏にある筋膜と呼ばれる厚い組織層の炎症または変性が含まれます。
この組織層は、歩いたり走ったりするときにバネとして機能します。ランニング量を急激に増やしすぎると、筋膜へのストレスが増大する可能性があります。ふくらはぎの筋肉の緊張や筋力低下も、足底筋膜炎のリスクにさらされる可能性があります。
通常、症状には次のようなものがあります。
- かかとの下または足の中程の痛み
- 徐々に発症する痛み
- 足の裏に灼熱感がある
- 朝になるとさらに悪化する痛み
- 長時間の活動後の痛み

7. 疲労骨折
疲労骨折は、繰り返しの応力や衝撃によって骨に生じるヘアライン状の亀裂です。ランナーの場合、疲労骨折は通常、足の甲、かかと、または下腿で発生します。
疲労骨折の疑いがある場合は、すぐに医師の診察を受けることをお勧めします。疲労骨折を診断するにはX線検査が必要です。
疲労骨折の症状には通常次のようなものがあります。
- 時間の経過とともに悪化する痛み。最初はほとんど目立たないかもしれませんが、痛みが進行すると、安静時にも感じられるようになります。
- 骨折部の腫れ、あざ、または圧痛
疲労骨折の治癒には通常 6 ~ 8 週間かかり、一定期間松葉杖の使用やギプスの着用が必要になる場合があります。

8.足首の捻挫
足首の捻挫は、脚と足首の間の靭帯が過度に伸びることによって引き起こされます。捻挫は足の外側で着地し、足首をひっくり返したときに起こりやすいです。
足首の捻挫に関連する一般的な症状は次のとおりです。
- 変色
- 痛み
- 腫れ
- あざ
- 限られた可動範囲
ほとんどの場合、足首の捻挫は休息、セルフケア、または理学療法によって改善します。治癒には数週間または数か月かかる場合があります。

その他の種類のランニング傷害
ランナーが経験しやすいその他の怪我には次のようなものがあります。
- 陥入爪。陥入爪は、爪の端が皮膚に食い込むことで起こります。足の爪に沿って痛みや炎症を引き起こす可能性があり、感染すると膿がにじみ出ることがあります。
- 滑液包炎。滑液包は、筋肉と腱の下にある液体で満たされた袋です。関節を滑らかにするのに役立ちます。ランニングによってこれらの嚢が繰り返し摩擦されると、腰や膝の周りに炎症を引き起こす可能性があります。
- 半月板断裂。半月板断裂とは、膝の軟骨の断裂を指します。関節がロックする感覚を引き起こすことがよくあります。
- 前方コンパートメント症候群。前コンパートメント症候群は、下腿の前部の筋肉が神経や血管を圧迫すると発生します。この症候群は医療上の緊急事態となる可能性があります。
- ふくらはぎの緊張。ランニングによる繰り返しの外傷は、ふくらはぎの張り(引っ張られたふくらはぎとも呼ばれます)を引き起こす可能性があります。

ランニング傷害の治療法の選択肢
何らかの痛みや不快感を感じたり、走るのが難しいと感じた場合は、医師に相談して適切な診断を受け、他の疾患を除外することをお勧めします。
多くの一般的なランニング傷害の場合、治療には次のものが含まれることがよくあります。
- 理学療法セッションと特定のエクササイズ
- RICEプロトコルに従う(休息、氷、圧迫、挙上)
- アスピリンやイブプロフェンなどの非ステロイド性抗炎症薬(NSAID)を服用している
- 走る頻度と距離を減らす
その他のより具体的な治療には次のようなものがあります。
- ランナー膝の場合:大腿四頭筋と股関節の筋肉を強化し、硬い大腿四頭筋やふくらはぎをストレッチし、矯正靴を着用します。
- アキレス腱炎の場合:ふくらはぎのストレッチやマッサージ
- IT バンド症候群の場合:毎日の IT バンドのストレッチと股関節の筋肉の強化
- ハムストリングの怪我の場合:臀部の強化、ハムストリングのストレッチと強化、ランニングテクニックの変更
- 足底筋膜炎の場合:ふくらはぎをストレッチして強化する
- 疲労骨折の場合:松葉杖、ギプス、または手術
- 足首の捻挫の場合:足首を強化するエクササイズ

怪我予防のヒント
ランニング中の怪我は誰にでも起こる可能性がありますが、次のヒントを参考にすると怪我のリスクを最小限に抑えることができます。
- 準備し始める。ランニングを始める前に、簡単なジョギングや腕や脚のスイングなどの動的可動ストレッチを5 ~ 10 分間行ってウォームアップしてください。
- ランニングボリュームをゆっくり上げてください。多くのランナーは 10% ルールに従っています。これは、毎週のランニング量を一度に 10% 以上増やさないことを意味します。
- しつこい怪我には気をつけてください。深刻な問題に発展しないように、しつこい怪我はすぐに休んでください。理学療法士は適切な診断を行い、カスタマイズされた治療計画を提供します。
- テクニックを磨いてください。ランニングテクニックが不十分だと、筋肉や関節へのストレスが増大する可能性があります。ランニングコーチと協力したり、ランニングテクニックを撮影したりするだけでも上達に役立ちます。
- 腰を強化します。膝や足首を保護するために、グルートブリッジや片足スクワットなどの安定性を高めるエクササイズをトレーニング プログラムに組み込んでください。
- 柔らかい表面を使用してください。芝生、ゴムクローラ、砂、砂利の上を走ると、舗装された道を走るよりも関節に負担がかかりやすくなります。長期にわたる怪我に対処している場合は、痛みが治まるまで柔らかい路面で走ってみてください。
- クロストレーニングを検討してください。サイクリングや水泳など、衝撃の少ないトレーニングをスケジュールに追加すると、ランニングによる繰り返しの衝撃から関節を休ませながら、有酸素運動能力を向上させることができます。

結論
多くのランナーは、いつかは怪我をします。ランニングによって怪我をする最も一般的な部位には、膝、脚、足が含まれます。
ランニング中に何らかの痛みや不快感を感じた場合は、医師に相談して適切な診断を受け、他の症状を除外することが最善です。
RICE プロトコルを使用し、痛みに対して NSAID を服用し、理学療法計画に従い、的を絞った運動を行うことは、多くの一般的なランニング傷害から回復するのに役立ちます。ランニングの頻度と距離を減らすことも、より早く回復するのに役立ちます。
参考文献
- https://www.ncbi.nlm.nih.gov/pmc/articles/PMC4338213/
- https://www.ncbi.nlm.nih.gov/pmc/articles/PMC4473093/
ランニングで最も一般的な8つの怪我・関連動画
免責事項: 健康百科事典ブログは、すべての情報が事実に基づき、包括的で最新のものであるよう努めています。しかし、この記事は、資格を持つ医療専門家の知識や専門性の代替として使用されるべきではありません。薬を服用する前には、必ず医師または他の医療専門家に相談してください。ここに記載されている情報は変更される可能性があり、すべての可能な用途、指示、注意事項、警告、薬物相互作用、アレルギー反応、副作用を網羅することを意図しているわけではありません。特定の薬物または薬物の組み合わせに関する警告や情報が記載されていない場合でも、その薬物や組み合わせがすべての患者やすべての用途において安全、有効、適切であることを意味するものではありません。
